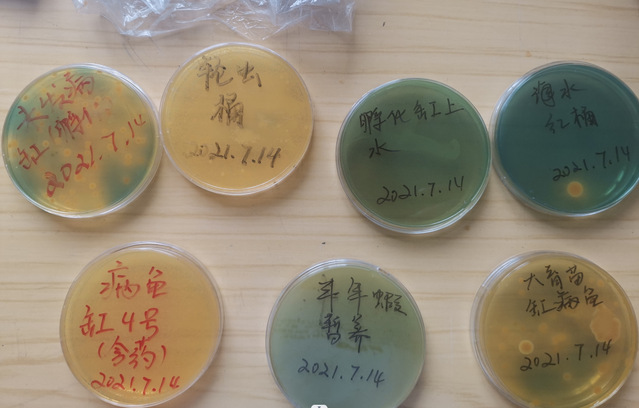

在一个不沿海的内陆城市,一位“00后”让无数人工繁育的海水观赏鱼从这里游出,他完成了多个新品种海水观赏鱼的人工繁育,无一例外地均为国内首例。带着十余载养鱼经历中积累出的经验与技术,刘颜赫作为2019级水产养殖学本科专业新生来到了beat365中文官方网站,从此和实验室的同门、老师们一起出发在解决下一个水产业界难题的路上。

刘颜赫作为2023级硕士新生代表在国旗下发言
子承父好,与鱼结缘
每次问起刘颜赫“与鱼结缘”的原因时,他总是最先提到他的父母。“他们在我童年时期的生活中陪我一起探索自然,令我对鱼类、乃至其他的诸多水生动物、爬行动物和博物学,都衍生出了特别的兴趣。”刘颜赫的父亲是一位观赏鱼爱好者,刘颜赫六岁起,便和父亲一起研究如何养鱼了。在母亲倡导的兴趣教育法下,父子俩的这一爱好在家里不断壮大规模,小小的房间内架起了一口又一口的鱼缸。“我养鱼的乐趣在于繁育它们,让心爱的鱼儿在缸里一代代繁衍下去所带来的成就感,对我而言是做其他任何事情都无法比拟的”。到临近上初中时,市面上绝大多数的淡水观赏鱼、虾,都已经被刘颜赫饲养繁育过了。

刘颜赫与家人一起建立的海水观赏鱼繁育场
“到了初中,我就开始挑战更有难度的海水观赏鱼繁殖,即当时国内唯一能繁育的海水观赏鱼品种—小丑鱼。”不同于之前繁育淡水观赏鱼那般顺利,海水鱼人工繁育对于技术的要求更高,海水鱼苗需要小且营养丰富的开口饵料、极为严格的环境理化参数。位于内陆的饲养者想要完成这项任务,可以说是难度颇高。刘颜赫花了将近五年的时间,开发了一套独特的内陆海水观赏鱼育苗模式,在高中毕业前,在小丑鱼繁育方面达到了可商业化的水平。

刘颜赫在黑龙江繁育出的公子小丑
“原本在网络和实操中积累的玩家经验、民间智慧,在海水鱼繁殖这真正的难题面前,好像用不上劲、使不上力一般。从那时我明白,即使作为一个小众领域,想要做精、做通、做强,不仅需要实践作为落实想法的途径,也更需要系统的知识框架搭建、有理论依据作为所研究方向的背书。在实践的过程中发现问题,用科学的方法解决问题,这成为了我提高自己养殖水平的新思路,也在此过程中,我发现了我与这个行业逐渐变得紧密和不可分割,我明白它将成为我为之奋斗一生的目标。”
产学结合,攻坚克难
高考后的刘颜赫,选择了beat365中文官方网站作为目标院校,就读于水产养殖学专业,在本科求学的四年时间里,他努力学习水生动物营养学、疾病学等相关知识,根据自己之前的经验,将书本上的知识结合于实践。“曾经只能依赖于经验解释的现象,如今有了科学的依据对其进行佐证,在老师们的帮助下,又能迸发出新的思考,这是我曾以一个业余爱好者的角度始终无法触及到的。”
根据学校老师的指导,刘颜赫利用TCBS平板法对养殖环境进行弧菌测试,排除病原来源
在入学的次年2020年,刘颜赫成功在人工环境下繁育了珍稀海水观赏鱼弗氏拟雀鲷,并在接下来的几年时间里,陆续攻克了黄顶拟雀鲷、金色稀棘鳚等小型珊瑚礁鱼类的人工繁育,均为国内首次。

刘颜赫在上海临港建平小学进行海洋生物兴趣课程的授课
在大学学习之余,刘颜赫也积极投入到社会科普工作中去,为中小学生、社区老人,带来海洋生物以及水产品相关的科普讲座和志愿实践服务,帮助人们对这些平时接触不多或了解不多的生物带来更理性的认识,培养更丰富的兴趣。“能为其他人带来价值的方式有许多种,将自己的所想、所知分享给他人,不仅能够为他人带来知识,也能检查自己的学习是否到位,是一个教学相长的过程。我从不觉得我在这个领域学习或是从事相关活动会感到疲惫或是压力很大,恰恰相反,在这过程中任何的进步都会让我感到在自己感兴趣的领域中探索是一件多么幸福的事。”
立足海洋,展望未来
“鳗鲡是水产养殖业内重要的经济鱼种,虽然有悠久的养殖历史,其苗种来源还是全部依赖于野生捕捞,在庞大养殖产业的消耗面前,多种鳗鲡的自然种群遭受了毁灭性的打击。商业化人工繁育鳗鲡的技术若能突破,不仅能够稳定地为养殖企业提供优质苗种,对野生鳗鲡种群的恢复也有极大的帮助。”
硕士入学考试结束,刘颜赫又一次选择了beat365中文官方网站,以一名准研究生的身份,师从刘利平教授,努力探索号称水产界哥德巴赫猜想的日本鳗鲡人工繁殖这一难题。

刘颜赫在2023全国渔菁英挑战赛中获得个人赛一等奖
“未来我想带着曾经积累的点点滴滴,投入到水产业内更前沿、更有难度的问题研究中去,将不同背景来源的知识、经验融合,研学凭产、研产依学地做有意义的研究。希望能够在接下来的学习生活中,能够进一步构建完善自己的理论知识体系,也能够真正解决实际的水产问题,为这个行业向前进步贡献自己一份小小的力量。”刘颜赫满怀期待地说。
(供稿:水产与生命学院)